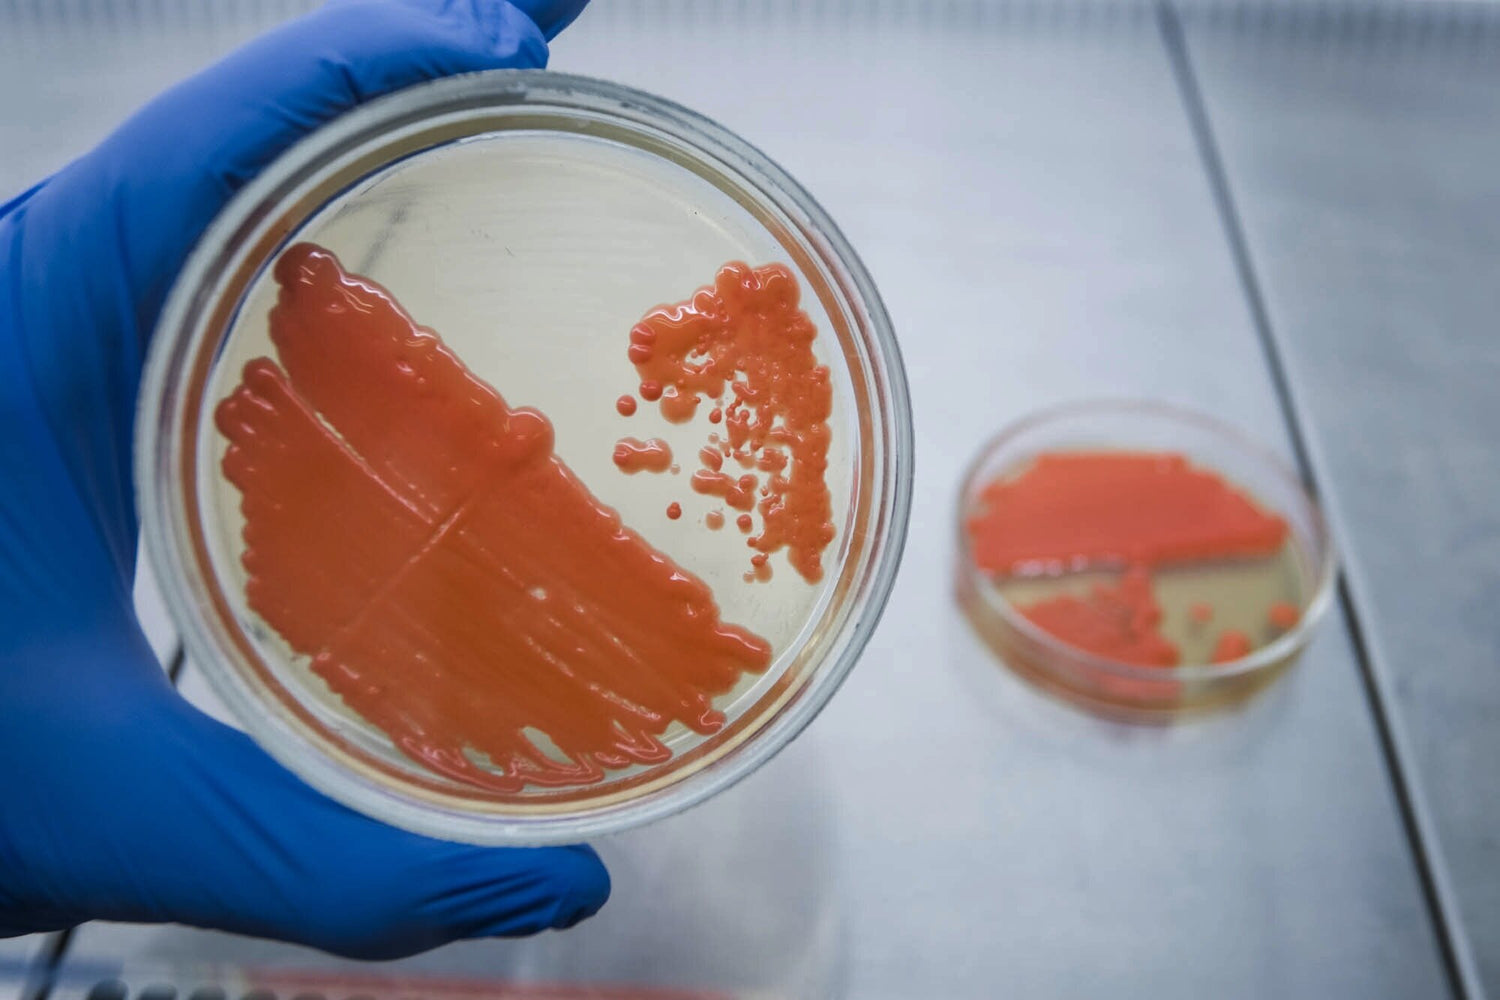

Fresh Culture Media Manufactured For Your Lab’s Needs
Your Results Are Critical
Edge Biologicals manufactures freshly prepared standard and specialty culture media so that your lab can generate accurate data. We prepare and ship orders accurately and on-time with no minimum order quantities.
Plated
Experience the convenience of plated culture media for seamless lab processes. Quality products for precise experimentation.

Tubed
Enhance your laboratory processes with our premium tubed culture media, ensuring accurate and reproducible outcomes every time.

Bottled
Maximize the efficiency of your lab work with our premium bottled culture media. Engineered for superior performance and reproducible results.
Products At A Glance
Search our extensive catalog below
-
0.1% Peptone Water (20/CS)
Regular price From $120.97 USDRegular priceUnit price / per -
0.1% Peptone Water (99ML) 48/Case
Regular price $85.00 USDRegular priceUnit price / per -
0.1% Peptone Water (9ML)
Regular price $84.80 USDRegular priceUnit price / per -
1-Propanol Acser 1L
Regular price $200.00 USDRegular priceUnit price / per -
11X300Mm Jktd Chrom Coler COLUMN
Regular price $415.00 USDRegular priceUnit price / per -
20% Salt Agar Plate 10/pk
Regular price $18.00 USDRegular priceUnit price / per -
3M Clean-Trace Luminometer
Regular price $5,000.00 USDRegular priceUnit price / per -
3M™ Petrifilm® Environmental Listeria Plates 6447, 50 each/case
Regular price $434.56 USDRegular priceUnit price / per
Brands We Distribute
-
Neogen - 3M
Explore Neogen (Formerly 3M) products from Petrifilm to Clean Trace Kits.
-
Microbiologics
UVBio Tag, EZ-Accu Shot, and more!
-
SARSTEDT
Serological Pipettes, Container Closures, Tubes, and Bottles

SARSTEDT PROMO
Order any Serological Pipette and receive an Automatic-Sarpette FREE
Reference Promo Code WC on your order and add Automatic-Sarpette® (90.189.203) at $0.